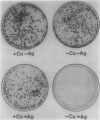
134
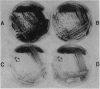
135

Abstract
In this study, we have addressed the capacity of the green alga Chlamydomonas reinhardtii to produce metal-binding peptides in response to stress induced by the heavy metals Cd2+, Hg2+, and Ag+. Cells cultured in the presence of sublethal concentrations of Cd2+ synthesized and accumulated oligopeptides consisting solely of glutamic acid, cysteine, and glycine in an average ratio of 3:3:1. Cadmium-induced peptides were isolated in their native form as higher molecular weight peptide-metal complexes with an apparent molecular weight of approximately 6.5 × 103. The isolated complex bound cadmium (as evidenced by absorption spectroscopy) and sequestered (with a stoichiometry of 0.7 moles of cadmium per mole of cysteine) up to 70% of the total cadmium found in extracts of cadmium-treated cells. In Hg2+-treated cells, the principal thiol-containing compound induced by Hg2+ ions was glutathione. It is possible that glutathione functions in plant cells (as it does in animal cells) to detoxify heavy metals. Cells treated with Ag+ ions also synthesized a sulfur-containing component with a charge to mass ratio similar to Cd2+-induced peptides. But, in contrast to the results obtained using Cd2+ as an inducer, these molecules did not accumulate to significant levels in Ag+-treated cells. The presence of physiological concentrations of Cu2+ in the growth medium blocked the synthesis of the Ag+-inducible component(s) and rendered cells resistant to the toxic effects of Ag+, suggesting competition between Cu2+ and Ag+ ions, possibly at the level of metal uptake.
Full text
PDF









Images in this article
Selected References
These references are in PubMed. This may not be the complete list of references from this article.
- Anderson M. E. Determination of glutathione and glutathione disulfide in biological samples. Methods Enzymol. 1985;113:548–555. doi: 10.1016/s0076-6879(85)13073-9. [DOI] [PubMed] [Google Scholar]
- Arnon D. I. COPPER ENZYMES IN ISOLATED CHLOROPLASTS. POLYPHENOLOXIDASE IN BETA VULGARIS. Plant Physiol. 1949 Jan;24(1):1–15. doi: 10.1104/pp.24.1.1. [DOI] [PMC free article] [PubMed] [Google Scholar]
- Bonner W. M., Laskey R. A. A film detection method for tritium-labelled proteins and nucleic acids in polyacrylamide gels. Eur J Biochem. 1974 Jul 1;46(1):83–88. doi: 10.1111/j.1432-1033.1974.tb03599.x. [DOI] [PubMed] [Google Scholar]
- CECIL R. The quantitative reactions of thiols and disulphides with silver nitrate. Biochem J. 1950 Nov-Dec;47(5):572–584. doi: 10.1042/bj0470572. [DOI] [PMC free article] [PubMed] [Google Scholar]
- Delhaize E., Jackson P. J., Lujan L. D., Robinson N. J. Poly(gamma-glutamylcysteinyl)glycine Synthesis in Datura innoxia and Binding with Cadmium : Role in Cadmium Tolerance. Plant Physiol. 1989 Feb;89(2):700–706. doi: 10.1104/pp.89.2.700. [DOI] [PMC free article] [PubMed] [Google Scholar]
- ELLMAN G. L. Tissue sulfhydryl groups. Arch Biochem Biophys. 1959 May;82(1):70–77. doi: 10.1016/0003-9861(59)90090-6. [DOI] [PubMed] [Google Scholar]
- Freedman J. H., Ciriolo M. R., Peisach J. The role of glutathione in copper metabolism and toxicity. J Biol Chem. 1989 Apr 5;264(10):5598–5605. [PubMed] [Google Scholar]
- Griffith O. W., Meister A. Potent and specific inhibition of glutathione synthesis by buthionine sulfoximine (S-n-butyl homocysteine sulfoximine). J Biol Chem. 1979 Aug 25;254(16):7558–7560. [PubMed] [Google Scholar]
- Grill E., Löffler S., Winnacker E. L., Zenk M. H. Phytochelatins, the heavy-metal-binding peptides of plants, are synthesized from glutathione by a specific gamma-glutamylcysteine dipeptidyl transpeptidase (phytochelatin synthase). Proc Natl Acad Sci U S A. 1989 Sep;86(18):6838–6842. doi: 10.1073/pnas.86.18.6838. [DOI] [PMC free article] [PubMed] [Google Scholar]
- Grill E., Winnacker E. L., Zenk M. H. Phytochelatins, a class of heavy-metal-binding peptides from plants, are functionally analogous to metallothioneins. Proc Natl Acad Sci U S A. 1987 Jan;84(2):439–443. doi: 10.1073/pnas.84.2.439. [DOI] [PMC free article] [PubMed] [Google Scholar]
- Grill E., Winnacker E. L., Zenk M. H. Phytochelatins: the principal heavy-metal complexing peptides of higher plants. Science. 1985 Nov 8;230(4726):674–676. doi: 10.1126/science.230.4726.674. [DOI] [PubMed] [Google Scholar]
- Hurst R., Schatz J. R., Matts R. L. Inhibition of rabbit reticulocyte lysate protein synthesis by heavy metal ions involves the phosphorylation of the alpha-subunit of the eukaryotic initiation factor 2. J Biol Chem. 1987 Nov 25;262(33):15939–15945. [PubMed] [Google Scholar]
- Jackson P. J., Unkefer C. J., Doolen J. A., Watt K., Robinson N. J. Poly(gamma-glutamylcysteinyl)glycine: its role in cadmium resistance in plant cells. Proc Natl Acad Sci U S A. 1987 Oct;84(19):6619–6623. doi: 10.1073/pnas.84.19.6619. [DOI] [PMC free article] [PubMed] [Google Scholar]
- Karin M. Metallothioneins: proteins in search of function. Cell. 1985 May;41(1):9–10. doi: 10.1016/0092-8674(85)90051-0. [DOI] [PubMed] [Google Scholar]
- Krotz R. M., Evangelou B. P., Wagner G. J. Relationships between Cadmium, Zinc, Cd-Peptide, and Organic Acid in Tobacco Suspension Cells. Plant Physiol. 1989 Oct;91(2):780–787. doi: 10.1104/pp.91.2.780. [DOI] [PMC free article] [PubMed] [Google Scholar]
- Mendum M. L., Gupta S. C., Goldsbrough P. B. Effect of glutathione on phytochelatin synthesis in tomato cells. Plant Physiol. 1990 Jun;93(2):484–488. doi: 10.1104/pp.93.2.484. [DOI] [PMC free article] [PubMed] [Google Scholar]
- Merchant S., Bogorad L. Regulation by copper of the expression of plastocyanin and cytochrome c552 in Chlamydomonas reinhardi. Mol Cell Biol. 1986 Feb;6(2):462–469. doi: 10.1128/mcb.6.2.462. [DOI] [PMC free article] [PubMed] [Google Scholar]
- Murasugi A., Wada C., Hayashi Y. Cadmium-binding peptide induced in fission yeast, Schizosaccharomyces pombe. J Biochem. 1981 Nov;90(5):1561–1564. doi: 10.1093/oxfordjournals.jbchem.a133627. [DOI] [PubMed] [Google Scholar]
- Mutoh N., Hayashi Y. Isolation of mutants of Schizosaccharomyces pombe unable to synthesize cadystin, small cadmium-binding peptides. Biochem Biophys Res Commun. 1988 Feb 29;151(1):32–39. doi: 10.1016/0006-291x(88)90555-4. [DOI] [PubMed] [Google Scholar]
- Reese R. N., Mehra R. K., Tarbet E. B., Winge D. R. Studies on the gamma-glutamyl Cu-binding peptide from Schizosaccharomyces pombe. J Biol Chem. 1988 Mar 25;263(9):4186–4192. [PubMed] [Google Scholar]
- Reese R. N., Wagner G. J. Effects of buthionine sulfoximine on cd-binding Peptide levels in suspension-cultured tobacco cells treated with cd, zn, or cu. Plant Physiol. 1987 Jul;84(3):574–577. doi: 10.1104/pp.84.3.574. [DOI] [PMC free article] [PubMed] [Google Scholar]
- Scheller H. V., Huang B., Hatch E., Goldsbrough P. B. Phytochelatin synthesis and glutathione levels in response to heavy metals in tomato cells. Plant Physiol. 1987 Dec;85(4):1031–1035. doi: 10.1104/pp.85.4.1031. [DOI] [PMC free article] [PubMed] [Google Scholar]
- Singhal R. K., Anderson M. E., Meister A. Glutathione, a first line of defense against cadmium toxicity. FASEB J. 1987 Sep;1(3):220–223. doi: 10.1096/fasebj.1.3.2887478. [DOI] [PubMed] [Google Scholar]
- Steffens J. C., Hunt D. F., Williams B. G. Accumulation of non-protein metal-binding polypeptides (gamma-glutamyl-cysteinyl)n-glycine in selected cadmium-resistant tomato cells. J Biol Chem. 1986 Oct 25;261(30):13879–13882. [PubMed] [Google Scholar]
- Vögeli-Lange R., Wagner G. J. Subcellular localization of cadmium and cadmium-binding peptides in tobacco leaves : implication of a transport function for cadmium-binding peptides. Plant Physiol. 1990 Apr;92(4):1086–1093. doi: 10.1104/pp.92.4.1086. [DOI] [PMC free article] [PubMed] [Google Scholar]
- Wagner G. J. Characterization of a cadmium-binding complex of cabbage leaves. Plant Physiol. 1984 Nov;76(3):797–805. doi: 10.1104/pp.76.3.797. [DOI] [PMC free article] [PubMed] [Google Scholar]
- Weber D. N., Shaw C. F., 3rd, Petering D. H. Euglena gracilis cadmium-binding protein-II contains sulfide ion. J Biol Chem. 1987 May 25;262(15):6962–6964. [PubMed] [Google Scholar]